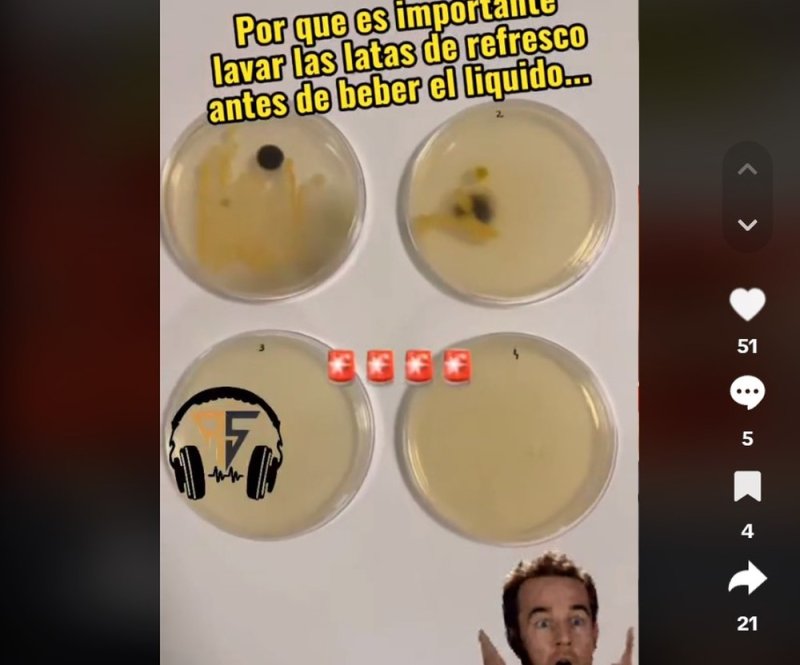

¿Con hongos y bacterias? Joven muestra qué tan sucias están las latas de refresco
TikTok se convirtió en una de las aplicaciones más vistas en todo el mundo. Millones de persona comparten constantes videos que logran sumar bastantes reproducciones; tal vez por eso, algunos jóvenes utilizan este sito como el nuevo buscador para responder a ciertas dudas. Entre todos los experimentos, en las últimas horas se comenzó a popularizar el ejercicio que hizo una persona para descubrir cuántas bacterias y hongos puede tener una lata de refresco.
El creador de contenido logró resumir, en menos de un minuto, todo el proceso para cultivar la superficie de los objetos y descubrir si tiene hongos y bacterias. Además de esto, el internauta lavó otra para ver si esto sí ayuda. Después de todo, el científico confirmó que sí hay hongos y bacterias en las latas.
La limpieza de la superficie ayudó mucho y demostró que esto mata la gran mayoría de bacterias que suelen estar en las latas. Hasta el momento, la grabación de los hechos cuenta con miles de reproducciones en le portal chino, TikTok.
“Mi sobrina compró una cola en lata, no la lavó, la destapó y así la consumió. Para nuestra tristeza y dolor ella murió porque la lata estaba sucia con orina”, “el orin de la rata es muy malo”, “esa clase de estudios falta en muchos productos consumidos a diario” o “Todo lo que se usa en la cocina, así esté limpio, se vuelve a lavar ante de usar porque no se sabe si algún roedor lo orinó”.
Con Información de Publimetro.
@puchinis79 #latasderefresco #higiene #viral #viralvideo #bacterias ? Mysterious - Andreas Scherren